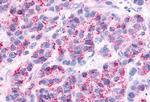
AVPR2 Antibody in Immunohistochemistry (Paraffin) (IHC (P))
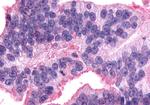
AVPR2 Antibody in Immunohistochemistry (Paraffin) (IHC (P))

Search
Invitrogen
AVPR2 Polyclonal Antibody
{{$productOrderCtrl.translations['antibody.pdp.commerceCard.promotion.promotions']}}
{{$productOrderCtrl.translations['antibody.pdp.commerceCard.promotion.viewpromo']}}
{{$productOrderCtrl.translations['antibody.pdp.commerceCard.promotion.promocode']}}: {{promo.promoCode}} {{promo.promoTitle}} {{promo.promoDescription}}. {{$productOrderCtrl.translations['antibody.pdp.commerceCard.promotion.learnmore']}}
产品信息
PA5-33350
种属反应
宿主/亚型
分类
类型
抗原
偶联物
形式
浓度
规格
纯化类型
保存液
内含物
保存条件
运输条件
RRID
产品详细信息
Percent identity with other species by BLAST analysis: Human, Chimpanzee, Gorilla, Orangutan, Gibbon, Monkey, Marmoset, Mouse, Rat, Hamster, Elephant, Rabbit (100%).
靶标信息
Avpr2 is a precursor protein consisting of arginine vasopressin and two associated proteins, neurophysin 2 and a glycopeptide, copeptin. Arginine vasopressin is a posterior pituitary hormone which is synthesized in the supraoptic nucleus and paraventricular nucleus of the hypothalamus. Along with its carrier protein, neurophysin 2, it is packaged into neurosecretory vesicles and transported axonally to the nerve endings in the neurohypophysis where it is either stored or secreted into the bloodstream. The precursor is thought to be activated while it is being transported along the axon to the posterior pituitary. Arginine vasopressin acts as a growth factor by enhancing pH regulation through acid-base transport systems. Avpr2 has a direct antidiuretic action on the kidney, and also causes vasoconstriction of the peripheral vessels. Avpr2 can contract smooth muscle during parturition and lactation. Avpr2 is also involved in cognition, tolerance, adaptation and complex sexual and maternal behaviour, as well as in the regulation of water excretion and cardiovascular functions. The activity of Avpr2 is mediated by G proteins which activate adenylate cyclase.
仅用于科研。不用于诊断过程。未经明确授权不得转售。
篇参考文献 (0)
生物信息学
蛋白别名: alternatively spliced; alternatively spliced; truncated 3' end; Antidiuretic hormone receptor; arginine vasopressin receptor 2; Avp2r; AVPR V2; G protein-coupled receptor; MGC126533; MGC138386; nephrogenic diabetes insipidus; Renal-type arginine vasopressin receptor; V2-renal V2R; V2R; Vasopressin receptor V2; Vasopressin V2 receptor
基因别名: ADHR; AVPR2; DI1; DIR; DIR3; I79_013962; ND1; NDI; NDI1; V2R; VPV2R
UniProt ID: (Human) P30518, (Mouse) O88721, (Rat) Q00788
Entrez Gene ID: (Human) 554, (Rabbit) 100352555, (Mouse) 12000, (Rat) 25108, (Chinese hamster) 100768840